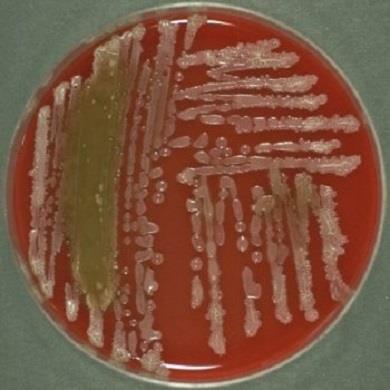
地衣芽孢杆菌的功效与用途

芽胞杆菌

蜡样芽胞杆菌
图片尺寸2896x5152
蜡样芽胞杆菌
图片尺寸5152x2896
芽孢杆菌
图片尺寸220x247
凝结芽孢杆菌
图片尺寸588x475
蜡样芽胞杆菌
图片尺寸2896x5152
破伤风芽胞
图片尺寸500x375
枯草芽胞杆菌——芽胞染色48h
图片尺寸480x360
p> a href="#" data-lemmaid="9492941">芽孢杆菌属 /a>( i>bacillus
图片尺寸1200x794
蜡样芽胞杆菌
图片尺寸2896x5152
芽胞杆菌工程化实验室简介
图片尺寸2272x1514
通过探索蜡状芽胞杆菌群的代谢途径,可以深入了解其适应不同环境和
图片尺寸2136x1280
种的特性,产生芽孢的杆菌中有需氧芽孢杆菌属和厌氧性梭状芽孢杆菌属
图片尺寸500x354
蜡样芽孢杆菌
图片尺寸392x328
endospore
图片尺寸800x600
地衣芽孢杆菌的功效与用途
图片尺寸390x390
梭状芽胞杆菌
图片尺寸1080x810
想问一下,cn培养基上长了革兰阴性的带芽胞的菌是什么菌呀
图片尺寸2336x4160
蜡样芽胞杆菌
图片尺寸800x600
地衣芽孢杆菌的介绍
图片尺寸466x322
枯草芽胞杆菌——芽胞染色48h
图片尺寸480x360